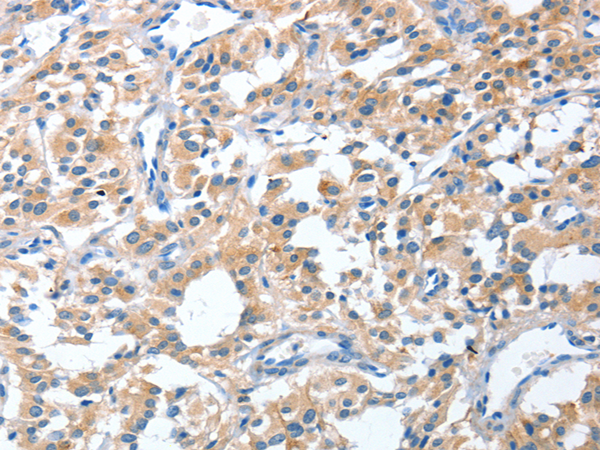

中文名稱:兔抗CGB3多克隆抗體
英文名稱: Anti-CGB3 rabbit polyclonal antibody
別 名: CGB3; CGB5; CGB7; CGB8; hCGB
相關(guān)類別: 一抗
抗 原: CGB3
宿 主: Rabbit
反應(yīng)種屬: Human
標(biāo) 記 物: Unconjugate
克隆類型: rabbit polyclonal
技術(shù)規(guī)格
|
Background: |
This gene is a member of the glycoprotein hormone beta chain family and encodes the beta 3 subunit of chorionic gonadotropin (CG). Glycoprotein hormones are heterodimers consisting of a common alpha subunit and an unique beta subunit which confers biological specificity. CG is produced by the trophoblastic cells of the placenta and stimulates the ovaries to synthesize the steroids that are essential for the maintenance of pregnancy. The beta subunit of CG is encoded by 6 genes which are arranged in tandem and inverted pairs on chromosome 19q13.3 and contiguous with the luteinizing hormone beta subunit gene. |
|
Applications: |
ELISA, WB, IHC |
|
Name of antibody: |
CGB3 |
|
Immunogen: |
Fusion protein of human CGB3 |
|
Full name: |
chorionic gonadotropin subunit beta 3 |
|
Synonyms: |
CGB; CGB5; CGB7; CGB8; hCGB |
|
SwissProt: |
P0DN86 |
|
ELISA Recommended dilution: |
1000-2000 |
|
IHC positive control: |
Human thyroid cancer and Human liver cancer |
|
IHC Recommend dilution: |
25-100 |
|
WB Predicted band size: |
18 kDa |
|
WB Positive control: |
Human placenta tissue |
|
WB Recommended dilution: |
200-1000 |

購物車
幫助
021-54845833/15800441009
